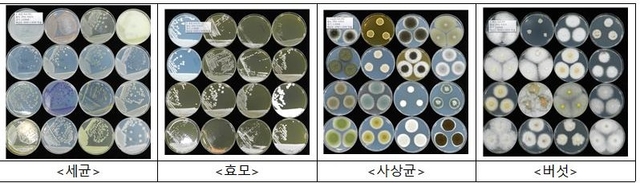

나고야의정서 발효로 국내 토착 미생물 요구가 늘 것으로 예상되는 가운데 농촌진흥청이 보유한 미생물 자원이 연구용으로 활발하게 분양돼 다양한 성과를 거두고 있다.
11일 농진청에 따르면 지난해 발효된 나고야의정서의 유예 기간이 오는 8월 끝나고 본격 시행될 예정이어서 국외 미생물 접근이 까다로워질 전망이다.
특히 생물자원에 대해 각 나라의 주권적 권리를 인정하고, 자원 이용으로 발생한 이익을 제공국과 공유하게 됨에 따라 자국의 생물자원을 확보·보존하고 활용 기반을 확대하는 것이 매우 중요해졌다.
이런 가운데 농진청에서 운영하는 미생물은행(KACC, Korean Agricultural Culture Collection)은 해마다 미생물 자원 2500여점을 연구용으로 분양해 가시적인 성과를 도출해 내고 있다.
지난 5년간 세균, 사상균, 효모, 버섯을 포함해 1만2000여점의 미생물이 분양됐다.
분양된 미생물은 연구용으로 활용되는데, 농촌진흥청 미생물은행에서 분양한 균주를 활용한 연구 결과가 지난 5년간 910여 편의 논문에 인용됐다.

건국대학교는 Aspergillus oryzae KACC 40247 균주를 분양 받아 콩에 처리했더니 의약용 이소플라본의 양이 증가했다고 보고했으며, 한경대학교는 분양 받은 방선균의 일종인 KACC 20028 균주가 인삼에서 고효율 진세노사이드의 양을 늘렸음을 확인했다.
미생물은행에는 발효식품 유래 미생물, 토양이나 공기 중에 살고 있는 미생물과 식물병 미생물, 야생버섯 등 미생물 8100여종 2만3000여점이 보존돼 있다.
이들 자원은 유전자를 분석해 종 동정이 이뤄지고 품질을 관리하기 때문에 믿고 이용할 수 있다.
영하 196℃ 액체질소 보존과 분말 형태의 동결건조 보존, 계대배양 보존 등으로 장기 보존이 가능하다.
미생물은행 보유 자원 중 공개 가능한 자원 1만2000여점에 대해서는 농업유전자원서비스 시스템에서 분양 신청을 하고 연구용으로 활용할 수 있다.
농진청 국립농업과학원 농업미생물과 권순우 농업연구관은 “국내 토착 미생물의 지속적인 확보와 활용으로 농업적 활용도를 높여 국외 자원 의존도를 낮춰가겠다”라고 말했다.



전체댓글 0